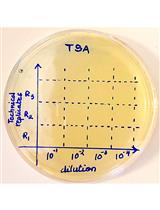

- Submit a Protocol
- Receive Our Alerts
- Log in
- /
- Sign up
- My Bio Page
- Edit My Profile
- Change Password
- Log Out
- EN
- EN - English
- CN - 中文
- Protocols
- Articles and Issues
- For Authors
- About
- Become a Reviewer
- EN - English
- CN - 中文
- Home
- Protocols
- Articles and Issues
- For Authors
- About
- Become a Reviewer
Isolation of Circulating Immune Complexes from TB Patient Serum for Serodiagnosis
Published: Vol 2, Iss 11, Jun 5, 2012 DOI: 10.21769/BioProtoc.188 Views: 13444

Protocol Collections
Comprehensive collections of detailed, peer-reviewed protocols focusing on specific topics
Related protocols

Platelet Migration and Bacterial Trapping Assay under Flow
Shuxia Fan [...] Florian Gaertner
Sep 20, 2018 6914 Views
Gentamicin Protection Assay to Determine the Number of Intracellular Bacteria during Infection of Human TC7 Intestinal Epithelial Cells by Shigella flexneri
Atin Sharma and Andrea Puhar
Jul 5, 2019 9737 Views

Generating Three-dimensional Human Granulomas in vitro to Study Mycobacterium tuberculosis-host Interaction
Ainhoa Arbués [...] Damien Portevin
Nov 20, 2020 4801 Views
Abstract
Estimation of circulating immune complex in tuberculosis patients has shown better insight to the infection. Isolating circulating immune complex helps quantifying both antigen and antibody in the serum. It’s a simple procedure to improve the sensitivity and specificity in serodiagnosis of tuberculosis. This protocol may be modified to detect antigen/antibody in other infectious diseases.
Keywords: Circulating Immune complexMaterials and Reagents
- Boric acid (Sigma-Aldrich, catalog number: B6768 )
- Disodium tetraborate (Borax) (Sigma-Aldrich, catalog number: 71996 )
- NaCI (Sigma-Aldrich, catalog number: S3014 )
- Polyethylene glycol (PEG 8000) (Sigma-Aldrich, catalog number: 89510 )
- Phosphate buffer saline (Life Technologies, Gibco®, catalog number: 20012-027 )
- NaHCO3 (Sigma-Aldrich, catalog number: S6014 )
- Na2CO3 (Sigma-Aldrich, catalog number: 330361 )
- BSA (Sigma-Aldrich, catalog number: A7030 )
- Tween 20 (Sigma-Aldrich, catalog number: P9416 )
- Antihuman affinipure IgG/lgA/lgM HRP [The Jackson Laboratory, USA, catalog number: 709-036-149 (IgG); 109-036-011 (IgA); 309-036-043 (IgM)]
- Na2HPO4 (Sigma-Aldrich, catalog number: S3264 )
- Citric acid (Sigma-Aldrich, catalog number: 251275 )
- O-Phenylenediamine (OPD) (Sigma-Aldrich, catalog number: P5412 )
- H2SO4 (Sigma-Aldrich, catalog number: 320501 )
- 0.1 M borate buffer (pH 8.4) (see Recipes)
- 7% polyethylene glycol (PEG) (see Recipes)
- Phosphate buffer saline (PBS) (see Recipes)
- 0.06 M Carbonate buffer (pH 9.6) (see Recipes)
- Blocking solution (see Recipes)
- Primary antibody (see Recipes)
- Secondary antibody (see Recipes)
- Substrate buffer (see Recipes)
- Substrate (see Recipes)
- Stop solution (see Recipes)
Equipment
- Refrigerated bench-top centrifuges
- 96 wells flat bottom ELISA plates (Nunc®, catalog number: 44-2404-21 )
- ELISA washer (Organon Teknika)
- Spectromax ELISA reader (Molecular Devices)
Procedure
- Circulating immune complex preparation
- Two hundred microliters of the test sera were centrifuged at 10,000 rpm for 5 min to remove any suspended particles.
- Next, 150 μl of the upper layer of the sera was collected and mixed with equal volume of 7% PEG. This gives a final concentration of 3.5% PEG in the sera.
- The sera were then vortexed and left overnight at 4 °C for precipiation of the immune complex.
- The next day, the precipitated immune complex was pelleted by centrifugation at 13,000 rpm for 10 min. The supernatant was discarded and the pellet was washed two times with 3.5% PEG.
- The circulating immune complex was finally dissolved in 0.01 M PBS and made up to the original volume of 150 μl.
- Two hundred microliters of the test sera were centrifuged at 10,000 rpm for 5 min to remove any suspended particles.
- Enzyme linked immunosorbent assay
- Polystyrene ELISA plates (96 wells, Nunc Maxisorp, flat bottom) were coated with 5 μg/ml of CFA, 1 μg/ml for 38 and 30 kDa and 0.2 μg/ml for 16 kDa of purified mycobacterial antigen in Carbonate buffer (pH 9.6). The plates were incubated with antigen overnight at 4 °C.
Note: Mycobacterial antigen is purified in the lab.
- The plates were washed four times with PBS buffer containing 0.1 % Tween 20 by the automatic ELISA washer.
- The non-specific sites in the wells were blocked with blocking solution for 1 h at 37 °C. After four washes with PBST, the plates were incubated for one hour at 37 °C with the precipitated circulating immune complex in 1/100 dilution. The plates were washed four times after 1 h incubation at 37 °C .The plates were then incubated with antihuman IgG peroxidase conjugate.
- At the end of 1 h of incubation at 37 °C and washing, the colour was developed by the addition of 100 μl of the substrate to each well.
- After arresting the reaction with 50 μl of 8 N H2SO4, the optical density was read in the Spectromax ELISA reader at 490 nm wavelength.
Note: IgA and IgM antibody determination were also carried out among the same patients and healthy subjects. For this, Antihuman IgA and Antihuman IgM were used in the dilution of 1:500 and 1:1, 000 respectively.
- Antibody estimation for IgG, A and M isotypes were carried out for CIC precipitated patients and normal healthy serum. The ELISA positivity was calculated based on the OD values of the mean plus two standard deviation of the normal healthy serum. This value was used as the cut off value to decide the Elisa positivity of the unknown serum.
- Polystyrene ELISA plates (96 wells, Nunc Maxisorp, flat bottom) were coated with 5 μg/ml of CFA, 1 μg/ml for 38 and 30 kDa and 0.2 μg/ml for 16 kDa of purified mycobacterial antigen in Carbonate buffer (pH 9.6). The plates were incubated with antigen overnight at 4 °C.
Notes
The samples to be assayed in a plate were randomly allocated to different wells within the plate and were also coded to conceal the identity of the specimens. In each of the experimental replicates of a positive reference serum (serum which has a strong positive response with high concentration of antibody from a smear microscopy confirmed tuberculous patient) was included. The mean value of the positive reference serum in independent experiments was taken as a constant reference value to assess plate-to-plate and day-to-day variations. Each plate had blank wells which represents the wells without antibody binding.
Recipes
- 0.1 M borate buffer (pH 8.4)
0.1 M boric acid 6.184 g
0.5 mM disodium tetraborate 9.5 g
75 mM NaCI 4.4 g
Made up to 1 L with distilled water
The pH should be 8.4 without adjusting
- 7% PEG
PEG 7 g
Borate buffer 100 ml
- 3.5% PEG
7% PEG 50 ml
Borate buffer 50 ml
- Phosphate buffer saline (PBS)
- 0.25 M PBS (25x stock solution)
- 0.01 M PBS (1x buffer)
- 0.25 M PBS (25x stock solution)
- 0.06 M Carbonate buffer (pH 9.6)
Solution A: [NaHCO3 (1 M)] 8.4 g/100 ml
Solution B: [Na2CO3 (1 M)] 10.6 g/100 ml
45.3 ml of A + 11 ml of B and made up to 1 L
- Blocking solution
1 % BSA in PBS+0.1% Tween 20
- Primary antibody
Circulating immune complex (CIC) 1:100 dilution
- Secondary antibody
Antihuman affinipure IgG/lgA/lgM HRP
- Substrate buffer (phosphate citrate buffer)
- Solution A
0.2 M Na2HPO4 8.517 g
Milli Q water (to make up to) 300 ml
- Solution B
0.1 M Citric acid 5.254 g
Milli Q water (to make up to) 250 ml
- 257 ml of solution A and 243 ml of solution B were mixed with 500 ml of Milli Q water to give 1 L of phosphate citrate buffer (pH 5.0)
- Solution A
- Substrate
OPD 10 mg (1 tablet)
Dissolved in 25 ml of 0.05 M phosphate-citrate buffer (pH 5.0)
30% H2O2 10 μl added to the above.
- Stop solution (8 N H2SO4)
36 N H2SO4 222.2 ml
Milli Q water (made upto) 1,000 ml
Acknowledgments
This protocol was adopted from previous work published by Raja et al. (1995).
References
- Raja, A., Ranganathan, U. D. and Ramalingam, B. (2006). Clinical value of specific detection of immune complex-bound antibodies in pulmonary tuberculosis. Diagn Microbiol Infect Dis 56(3): 281-287.
- Raja, A., Narayanan, P. R., Mathew, R. and Prabhakar, R. (1995). Characterization of mycobacterial antigens and antibodies in circulating immune complexes from pulmonary tuberculosis. J Lab Clin Med 125(5): 581-587.
- Uma Devi, K. R., Ramalingam, B., Brennan, P. J., Narayanan, P. R. and Raja, A. (2001). Specific and early detection of IgG, IgA and IgM antibodies to Mycobacterium tuberculosis 38 kDa antigen in pulmonary tuberculosis. Tuberculosis (Edinb) 81(3): 249-253.
Article Information
Copyright
© 2012 The Authors; exclusive licensee Bio-protocol LLC.
How to cite
Ranganathan, U. D., Bethunaickan, R. and Raja, A. (2012). Isolation of Circulating Immune Complexes from TB Patient Serum for Serodiagnosis. Bio-protocol 2(11): e188. DOI: 10.21769/BioProtoc.188.
Category
Immunology > Antibody analysis > Antibody detection
Immunology > Immune cell function > General
Immunology > Host defense > Human
Do you have any questions about this protocol?
Post your question to gather feedback from the community. We will also invite the authors of this article to respond.
Share
Bluesky
X
Copy link









